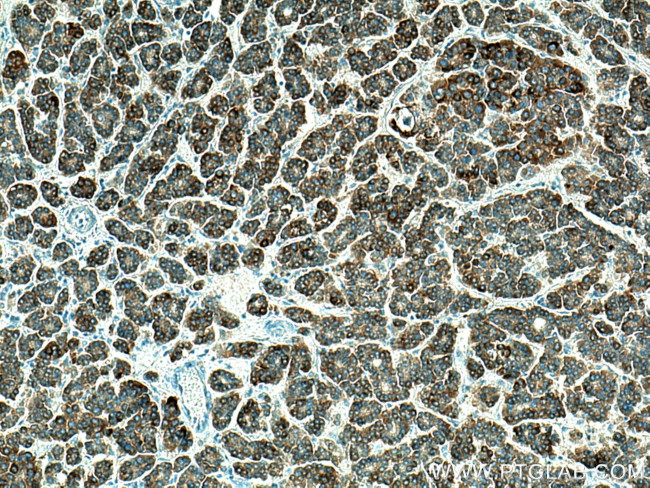
CXCL12/SDF-1 Antibody in Immunohistochemistry (Paraffin) (IHC (P))

Search
Proteintech
CXCL12/SDF-1 Polyclonal Antibody
{{$productOrderCtrl.translations['antibody.pdp.commerceCard.promotion.promotions']}}
{{$productOrderCtrl.translations['antibody.pdp.commerceCard.promotion.viewpromo']}}
{{$productOrderCtrl.translations['antibody.pdp.commerceCard.promotion.promocode']}}: {{promo.promoCode}} {{promo.promoTitle}} {{promo.promoDescription}}. {{$productOrderCtrl.translations['antibody.pdp.commerceCard.promotion.learnmore']}}
产品信息
17402-1-AP
种属反应
已发表种属
宿主/亚型
分类
类型
抗原
偶联物
形式
浓度
规格
纯化类型
保存液
内含物
保存条件
运输条件
产品详细信息
This antibody can detect all the isoforms of CXCL12/SDF1.
Immunogen sequence: SDGKPVSLS YRCPCRFFES HVARANVKHL KILNTPNCAL QIVARLKNNN RQVCIDPKLK WIQEYLEKAL NK (19-89 aa encoded by BC039893)
靶标信息
CXCL12 is a stromal cell-derived alpha chemokine member of the intercrine family. This gene product and its receptor CXCR4 can activate lymphocytes and have been implicated in the metastasis of some cancers such as breast cancer. Mutations in this gene are associated with resistance to human immunodeficiency virus type 1 infections. Multiple transcript variants encoding different isoforms have been found for this gene.
仅用于科研。不用于诊断过程。未经明确授权不得转售。
生物信息学
蛋白别名: 12-O-tetradecanoylphorbol 13-acetate repressed protein 1; AI174028; C Cmotif chemokine; C X C motif chemokine; C-X-C motif chemokine 12; CC motif chemokine; CCmotif chemokine; chemokine; chemokine (C-X-C motif) ligand 12; CXC; CXC motif chemokine; CXCL; CXCL12; hIRH; hSDF-1; Intercrine reduced in hepatomas; IRH; PBSF; Pre-B cell growth-stimulating factor; pre-B-cell growth-stimulating factor; SDF-1; SDF-1 delta; chemokine (C-X-C motif) ligand 12 transcript variant 5; SDF-1 epsilon; chemokine (C-X-C motif) ligand 12 transcript variant 6; SDF-1 gamma; chemokine (C-X-C motif) ligand 12 transcript variant 4; SDF-1 theta; chemokine (C-X-C motif) ligand 12 transcript variant 7; SDF-1a; SDF-1b; SDF1a; Stromal cell-derived factor 1; stromal cell-derived factor-1 alpha; Thymic lymphoma cell-stimulating factor; TLSF; TLSF-a; TLSF-b; Tlsfa; Tlsfb; TPAR1; unnamed protein product
基因别名: CXCL12; IRH; PBSF; SCYB12; SDF1; SDF1A; SDF1B; TLSF; TPAR1
UniProt ID: (Human) P48061, (Mouse) P40224
Entrez Gene ID: (Human) 6387, (Mouse) 20315